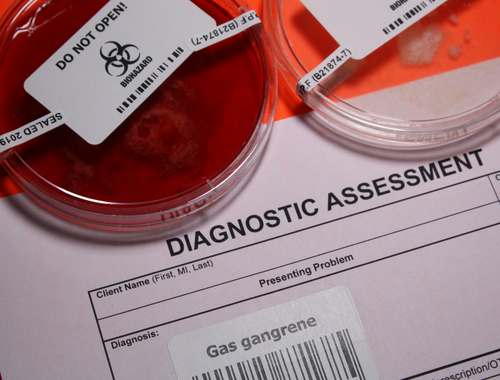

Difference Between Gas Gangrene and Necrotizing Fasciitis
Gas gangrene is a Clostridium perfringens infection that destroys the soft tissue and blood cells. It is a potentially fatal condition if not treated promptly. Gas gangrene can develop after deep penetrating injuries or abdominal surgery. Necrotizing fasciitis is a bacterial infection that causes the necrosis of the fatty subcutaneous skin layer and the vasculature-containing fascia. This condition develops from blunt force tissue injury, open wounds, and from cellulitis.
What is gas gangrene?
Definition:
Gas gangrene or clostridial myonecrosis is the toxin-induced destructive infection of the tissues. A bacteria called Clostridium releases toxins that break down blood cells, and soft tissue causing widespread skin discoloration, edema, and blisters.
Incidence:
Gas gangrene is an uncommon condition. It occurs in 1 per 100,000 individuals in the United States.
Risk factors:
Recurrent abdominal surgeries increase the risk of developing gas gangrene. Other conditions which put you at a higher risk of developing gas gangrene include colon carcinoma, diverticulitis, atherosclerosis, and uncontrolled diabetes.
Causes:
Deep penetrating injuries are the perfect habitat for C. perfringens growth. Traumatic injuries like these occur in road traffic accidents and stab wounds. Less frequent causes of gas gangrene include colon and gallbladder surgeries, gynecological procedures, tumors of the gastrointestinal tract, miscarriage, and uncontrolled diabetes.
Symptoms:
Typically, the affected skin in gas gangrene is discolored. It may be white, red, or purplish. Large blisters encompass the area and are filled with foul-smelling discharge. On touching the blisters, crepitus is appreciated. Symptoms of gas gangrene include severe pain at the wound site, fever, tachycardia, sweating, jaundice, and dizziness due to hypotension.
Diagnosis:
A healthcare provider will initially dig into your history and perform a physical examination of the wound region. In the case of suspected gas gangrene, blood, and pus cultures are sent and X-rays are performed to confirm gas under the dead tissue. Additional investigations such as computed tomography (CT) scan and magnetic resonance imaging (MRI) scans are ordered to decipher the extent of tissue damage.
Treatment:
A high dose of intravenous (IV) antibiotics along with surgical debridement is needed to control the infection from spreading and causing sepsis. There is evidence that hyperbaric oxygen therapy provides benefits in wound healing. Amputation is quite common as tissue damage is extensive in most cases.

What is necrotizing fasciitis?
Definition:
Necrotizing fasciitis also referred to as flesh-eating disorder, is an uncommon bacterial infection of subcutaneous tissue and fascia that causes the death of the tissue.
Risk factors:
Groups that are at an increased risk of developing necrotizing fasciitis include diabetics, hypertensive individuals, obese patients, adults greater than 50 years old, those with cellulitis, immunocompromised individuals, those with liver or kidney failure, and those taking injectable medications.
Symptoms:
Early-onset necrotizing fasciitis has the following symptoms: pain out of proportion confined to one area of the body, fever, rapidly spreading erythema, and edema. Later on, the symptoms become more severe and include induration or stiffness of the involved body part, paresthesia, blackening and bruising of the skin, blistering and foul-smelling discharge, and septicemia.
Diagnosis:
Necrotizing fasciitis is difficult to diagnose. The symptoms are vague and not so apparent on the overlying skin. The important investigation includes an X-ray of the affected region which will confirm gas buildup. A CT scan and MRI scans are further carried out to determine the depth of necrosed tissue and biopsies of the affected area.
Treatment:
Mortality rates are very high for the condition. IV broad-spectrum antibiotics and IV fluid resuscitation are super important to control the infection. Dead tissue is removed via debridement surgery. Extensive excision of the debris is carried out. Sometimes, hyperbaric oxygen therapy is in conjunction with antibiotics to promote rapid healing. Lastly, if the body part is unsalvageable, radical surgical intervention or amputation needs to be carried out.
Differences between gas gangrene and necrotizing fasciitis
Definition:
Gas gangrene or clostridial myonecrosis is the toxin-induced destruction of the tissues. A bacteria called Clostridium releases toxins that break down blood cells, and soft tissue causing widespread skin discoloration, edema, and blisters. Necrotizing fasciitis also referred to as flesh-eating disorder, is an uncommon bacterial infection of subcutaneous tissue and fascia that causes the death of the tissue.
Risk factors:
Recurrent abdominal surgeries increase the risk of developing gas gangrene. Other conditions which put you at a higher risk of developing gas gangrene include colon carcinoma, diverticulitis, atherosclerosis, and uncontrolled diabetes. Groups that are at an increased risk of developing necrotizing fasciitis include diabetics, hypertensive individuals, obese patients, adults greater than 50 years old, those with cellulitis, immunocompromised individuals, those with liver or kidney failure, and those taking injectable medications.
Symptoms:
Symptoms of gas gangrene include severe pain at the wound site, fever, tachycardia, sweating, jaundice, and dizziness due to hypotension. The affected skin has large, discharge-filled, foul-smelling blisters and is discolored. Symptoms of necrotizing fasciitis include severe pain, fever, rapidly spreading erythema, and edema, paresthesia, blackening and bruising of the skin, blistering and foul-smelling discharge, and septicemia.
Diagnosis:
A history and physical examination of the wound region are done to diagnose gas gangrene. Blood and pus cultures are ordered, and X-rays are performed to confirm gas under the dead tissue. Important investigations for necrotizing fasciitis include X-rays, CT scans, and MRI scans.
Treatment:
Management of gas gangrene is through a high dose of IV antibiotics and surgical debridement. Amputation is quite common as tissue damage is extensive in most cases. Treatment of necrotizing fasciitis includes IV broad-spectrum antibiotics, IV fluid resuscitation, and debridement surgery. and hyperbaric oxygen therapy. If the body part is unsalvageable, radical surgical intervention or amputation needs to be carried out.
Table of differences between gas gangrene and necrotizing fasciitis

FAQs
What is the difference between gangrene and necrotizing fasciitis?
Gangrene is the death of tissues due to deficient blood supply. Necrotizing fasciitis is a bacterial infection that causes the necrosis of the fatty subcutaneous skin layer and the vasculature-containing fascia.
Is gas gangrene necrotizing fasciitis?
No. Gas gangrene is a Clostridial infection whereas necrotizing fasciitis is a group A streptococcal infection.
How can you tell the difference between necrotizing fasciitis?
Biopsy and imaging studies are needed to tell if the infection is necrotizing fasciitis.
Is gangrene and necrosis the same thing?
Gangrene is the death of tissues due to deficient blood supply whereas necrosis is the phenomena of irreversible cell death.
What is the other name of necrotizing fasciitis?
Hemolytic streptococcal gangrene, Meleney ulcer, a hospital gangrene and synergistic necrotizing cellulitis are other names of necrotizing fasciitis.
What are the two types of necrotizing fasciitis?
Type I (polymicrobial) and type II (monomicrobial) are the two types of necrotizing fasciitis.
What is the most common cause of necrotizing fasciitis?
Open wounds and deep injuries are the most common causes of necrotizing fasciitis.
What is the most common way to get necrotizing fasciitis?
Through scrapes and cuts.
- Differences Between Reptiles and Amphibians - May 17, 2024
- Difference Between Ophthalmology and Optometry - May 15, 2024
- Difference Between Fear and Anxiety - April 2, 2024
Search DifferenceBetween.net :
Leave a Response
References :
[0]Green, Ronald J., Donald C. Dafoe, and Thomas A. Rajfin. "Necrotizing fasciitis." Chest 110.1 (1996): 219-229.
[1]Buboltz, Jerome B., and Heather M. Murphy-Lavoie. "Gas gangrene." (2019).
[2]Perry, Betsy N., and Waldo E. Floyd 3rd. "Gas gangrene and necrotizing fasciitis in the upper extremity." Journal of Surgical Orthopaedic Advances 13.2 (2004): 57-68.
